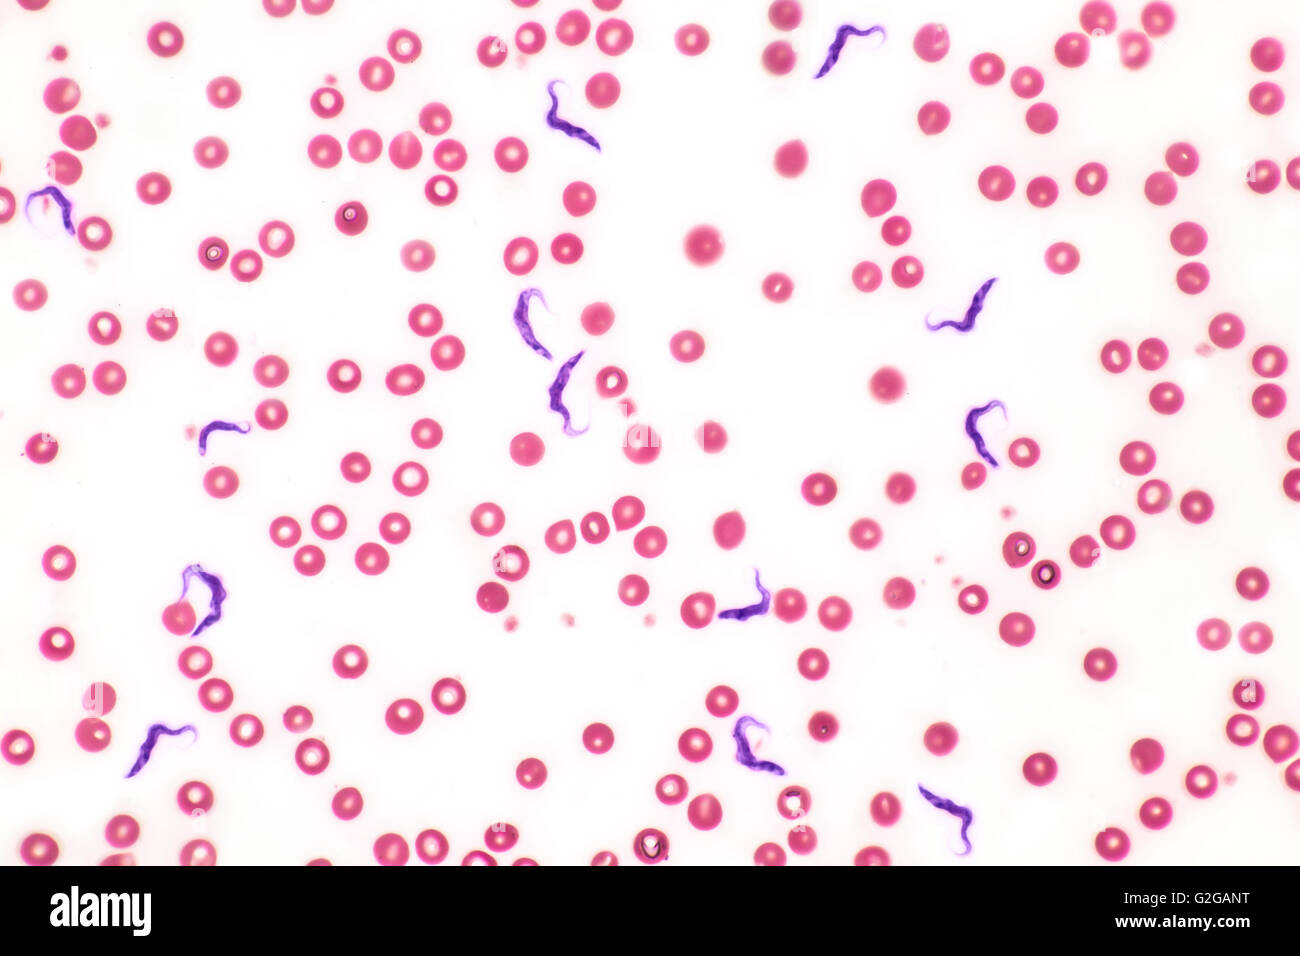
La malattia del sonno, tripanosomiasi parassita trypanosoma forme nel sangue umano, fotomicrografia in campo chiaro. Foto Stock
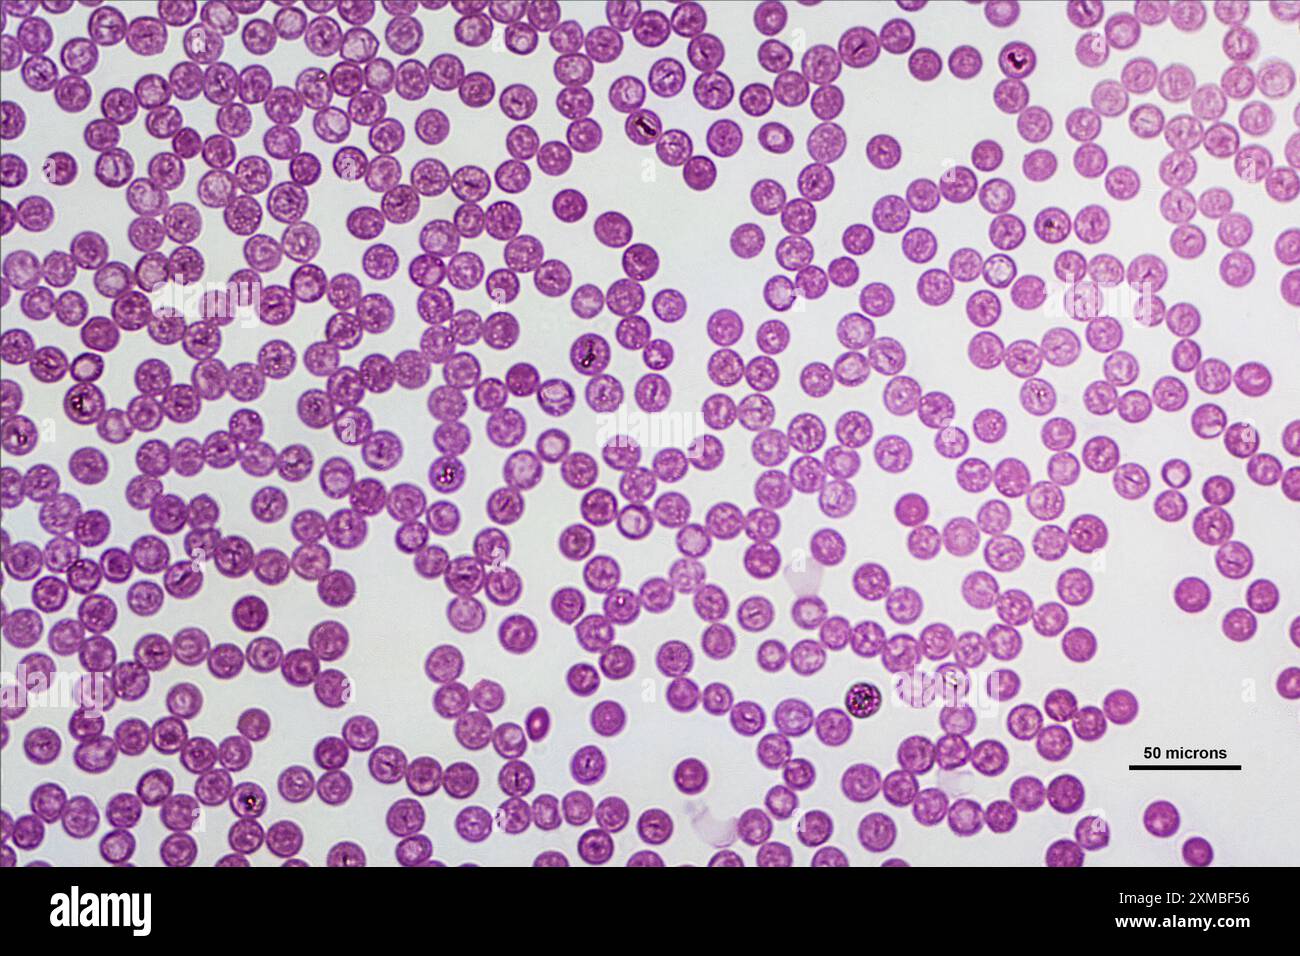
Cellule ematiche umane sotto microscopio leggero, colorate con colorazione Giemsa per ingrandimento di 40 volte Foto Stock
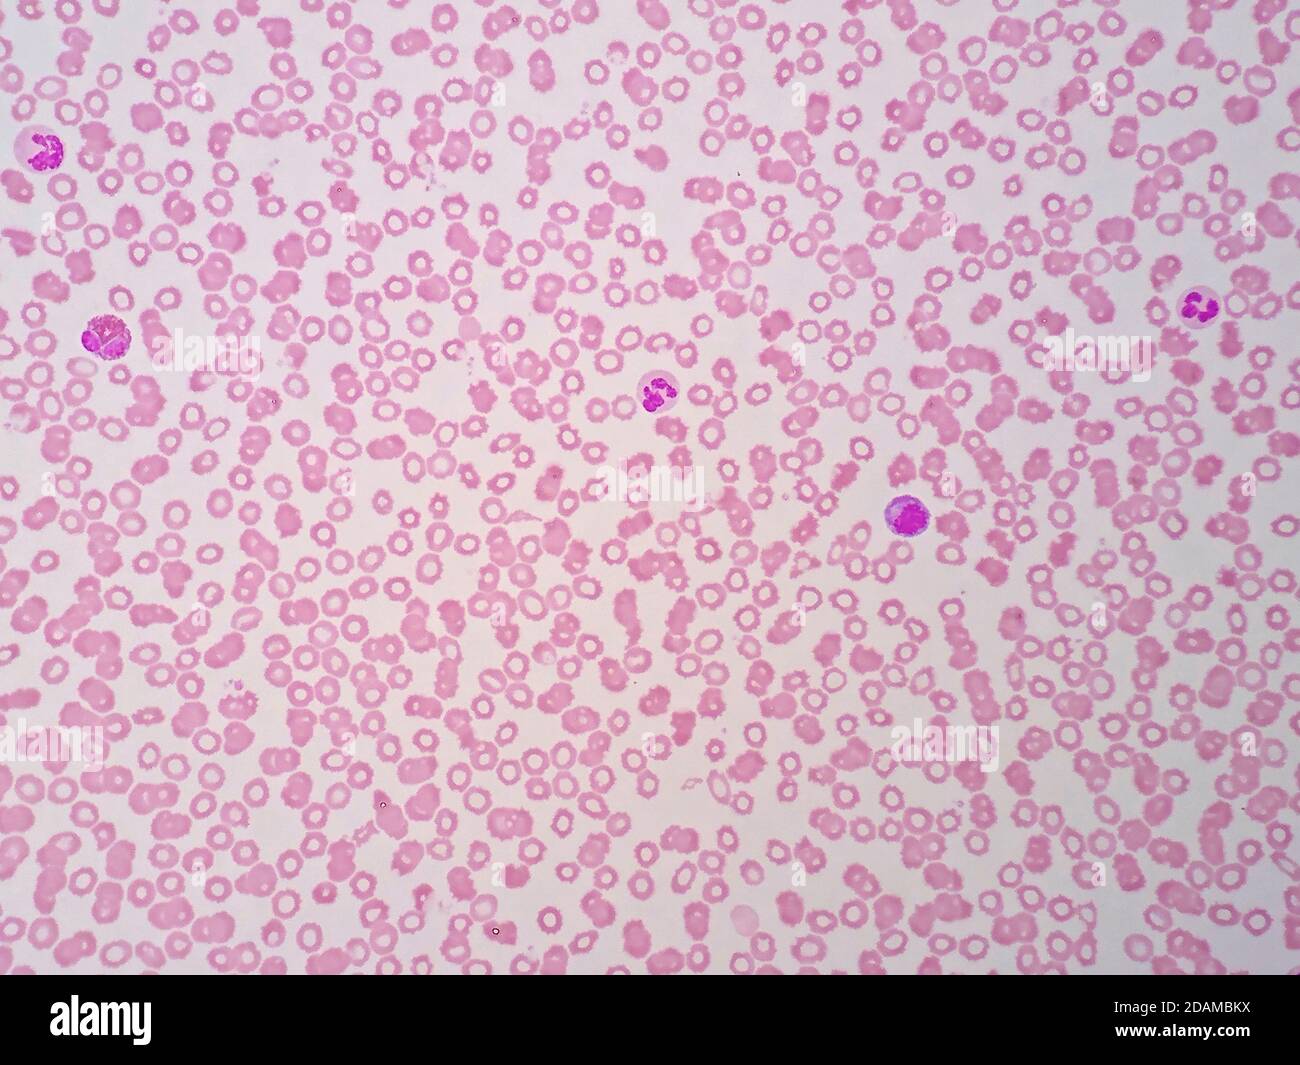
Cellule del sangue umane, micrografia leggera. Foto Stock
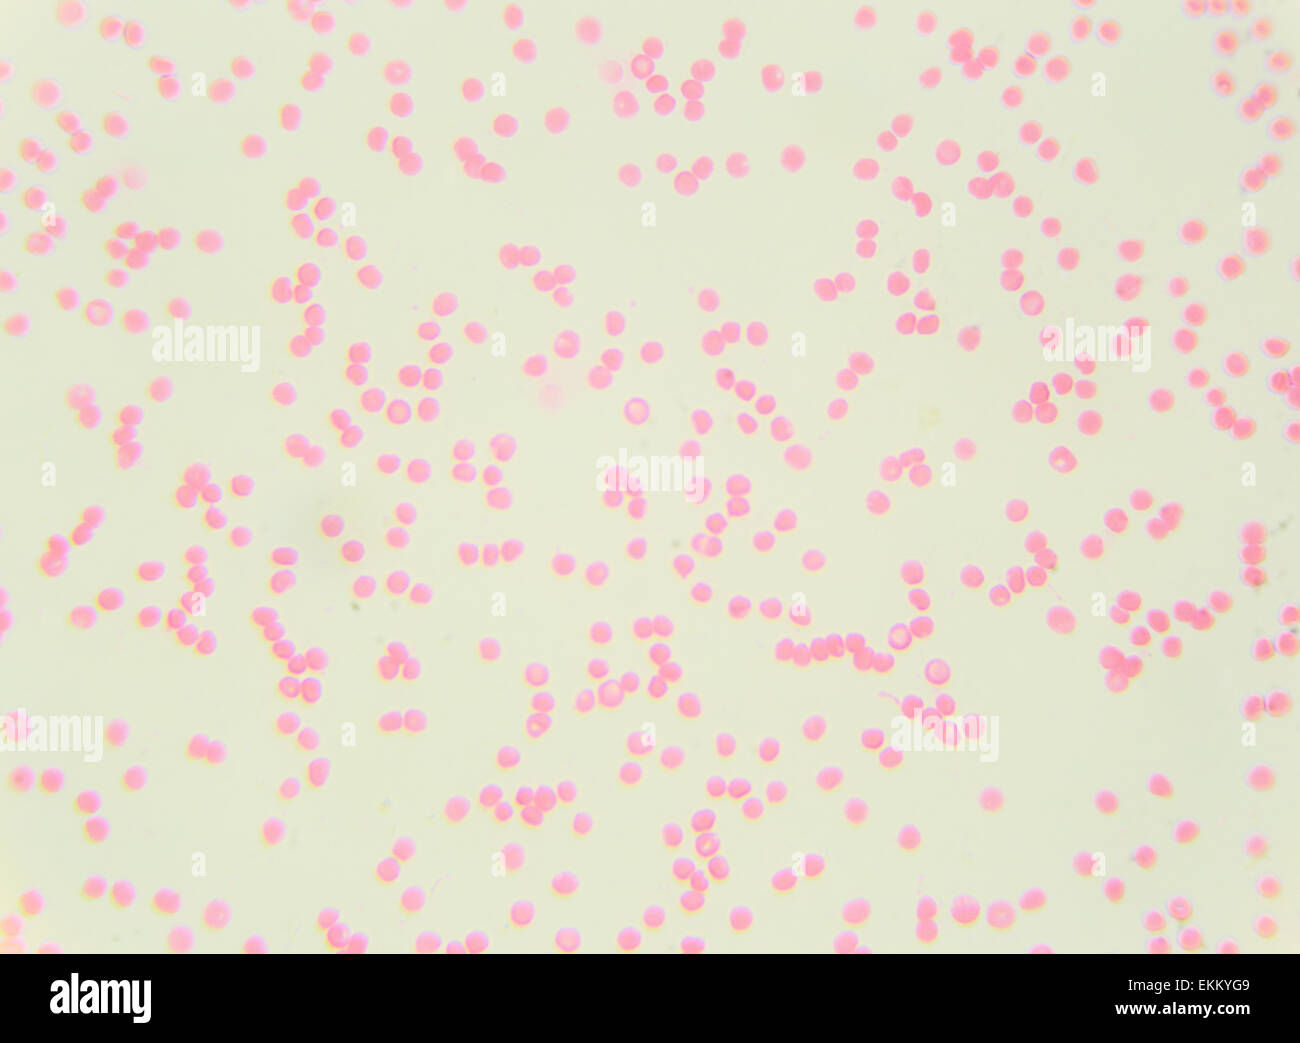
Sangue umano sotto il microscopio (striscio di sangue umano) 400x Foto Stock

Sangue umano Immagini Stock
(132,022)Filtri rapidi:
Sangue umano Immagini Stock

RFP4DX74–Cellule del sangue umano al microscopio. Ingrandite cospargere di globuli rossi nel plasma sanguigno. Il fluido corporeo negli esseri umani. Anatomia del corpo. Chiudere dall'alto.

RFF4KA9G–Di coagulo di sangue e trombosi Illustrazione medica nozione come un gruppo di cellule del sangue umano ammassate insieme da piastrine appiccicoso e
RM2BE0GCG–Cellule del sangue e piastrine. Micrografia elettronica a scansione (SEM) del sangue umano con globuli rossi e bianchi e piastrine. I globuli rossi (eritrociti) hanno una caratteristica forma biconcava-disco e sono numerosi. Queste grandi cellule contengono emoglobina, un pigmento rosso con cui l'ossigeno viene trasportato intorno al corpo. Sono più numerosi dei globuli bianchi, uno dei quali è visibile in questo campione. I globuli bianchi (leucociti) sono cellule arrotondate con proiezioni di microvilli dalla superficie cellulare. I leucociti svolgono un ruolo importante nella risposta immunitaria dell'organismo. Le piastrine sono cellule più piccole che

RMKTMMDN–Questa immagine raffigura un insetto del letto, un parassita comune noto per l'alimentazione con sangue umano. Le bolle rappresentano la sua reazione fisica dopo l'alimentazione, mentre il sangue viene digerito. Gli insetti del letto si trovano spesso nei letti e rappresentano una preoccupazione significativa per il controllo dei parassiti.

RFMF5AP9–Tecnico medico di preparazione di un campione di sangue umano per la sperimentazione clinica
RMG2GANT–La malattia del sonno, tripanosomiasi parassita trypanosoma forme nel sangue umano, fotomicrografia in campo chiaro.

RFHJ0B7W–Ago Ipodermico (26 gauge) sangue umano,color scanning electron microfotografia (SEM).le cellule rosse del sangue (RBC),o,gli eritrociti sono la maggior parte del tipo comune delle cellule di sangue nei vertebrati.Essi sono coinvolti nella fornitura di ossigeno ai tessuti del corpo.RBC prendere ossigeno nei polmoni o branchie rilasciarlo in tessuti mentre

RF3B2XC1M–Vasi sanguigni umani e organi principali con circolazione polmonare, circolazione venosa portale e circolazione sistemica.

RF2B09KE6–Vene del sangue umano, rappresentazione vettoriale dei vasi rossi. Vaso sanguigno e vaso di sagoma rossa cardiovascolare umano

RF2F8YW1P–Coaguli di sangue rischio per la salute o trombosi simbolo del concetto di illustrazione medica come un gruppo di cellule del sangue umane aggrovite insieme da piastrine appiccicose.

RFP4DX79–Cellule del sangue umano al microscopio. Alta ingrandito cospargere di globuli rossi nel plasma sanguigno. Il fluido corporeo negli esseri umani. Anatomia del corpo. Close up.

RMJ0804K–Il *vasi sanguigni Vesalius* si riferisce alle illustrazioni anatomiche di Andreas Vesalius, un pioniere anatomista del XVI secolo. I suoi disegni dettagliati dei vasi sanguigni umani rivoluzionarono la comprensione dell'anatomia umana, ponendo le basi per la moderna biologia e medicina.

RFMF5ENP–Tecnico medico di preparazione di un campione di sangue umano per la sperimentazione clinica
RF2DDTY05–Immagine del set di vena isolata su sfondo bianco. Raccolta del grafico del sistema del sangue umano. Vaso rosso, disegno delle arterie. Gruppo di icone anatomiche. Vect

RFHJ0B7X–Ago Ipodermico (26 gauge) con sangue umano,color scanning electron microfotografia (SEM).le cellule rosse del sangue (RBC),o,gli eritrociti sono la maggior parte del tipo comune delle cellule di sangue nei vertebrati.Essi sono coinvolti nella fornitura di ossigeno ai tessuti del corpo.RBC prendere ossigeno nei polmoni o branchie rilasciarlo in tessuti

RF2H5HJ8D–Anopheles gambiae mosquitoe, Satara, Maharashtra, India. Questi sono antropofilici e preferiscono il sangue umano rispetto ad altri animali

RMDD3K6B–Un grande Medico Ospedale Sacco riempito con sangue umano. Il retro della borsa è mostrato.

RF2G2D37R–Coaguli di sangue rischio per la salute o trombosi simbolo del concetto di illustrazione medica come un gruppo di coaguli di cellule di sangue umane coagulati insieme da piastrine appiccicose.

RFCWWC3N–Di circolazione di sangue umano simbolo con le cellule rosse del sangue che scorre attraverso le vene e umano sistema circolatorio che rappresenta un medico egli

RMT94YC2–La trasfusione di sangue tra due persone, J. Roussel, 1876. Inizio con Harvey's esperimenti con la circolazione del sangue, ricerca in materia di trasfusioni di sangue è iniziata nel XVII secolo, con successo esperimenti di trasfusione tra gli animali. Tuttavia, successivi tentativi da parte dei medici alla trasfusione di sangue animale in esseri umani hanno dato variabile, spesso mortali, i risultati. Trasfusioni precoce tra gli esseri umani sono stati rischiosa e molti hanno causato la morte del paziente. Non è stato fino al 1901, quando l'austriaco Karl Landsteiner scoperto il sangue umano e i gruppi che le trasfusioni di sangue è diventato più sicuro.

RMFJDM0C–In condizioni sperimentali l Aedes albopictus zanzara, noto anche come la tigre asiatica zanzara, ha dimostrato di essere un vettore del virus del Nilo occidentale. Aedes è un genere della famiglia Culicine di zanzare. James Gathany/CDC immagine

RF2B773GM–Una particella di sangue umano come appare quando trasparente e fluttuante; 2. La stessa, vista come illuminata; 3. La stessa, una metà illuminata; ed altra,

RFF1GME7–Una illustrazione medica, una vista al microscopio di un virus o di cellule di batteri e germi red cellule del sangue umano

RF2AX2G8D–Un primo piano di Coronavirus 2019-nCoV un virus influenzale infettivo che causa malattie respiratorie. Campioni di sangue umano in un laboratorio medico. 3d illustrazione

RF2BGHH8P–Vaso sanguigno umano con globuli rossi. Vena del sangue con macro eritrociti nell'illustrazione del vettore isolato dal plasma. Sistema vascolare, flusso sanguigno umano, microscopico cardiovascolare

RMDD44A8–Un grande Medico Ospedale Sacco riempito con sangue umano. La parte anteriore del sacchetto viene mostrato con un bianco white label.

RMKBYECK–"NSRW A Collateral Vascular Bundle" è un'illustrazione anatomica dettagliata che mostra la struttura di un bundle vascolare. Questo diagramma è significativo per la comprensione dei sistemi circolatori umani o animali.

RF2WA22WB–Pressione sanguigna e pressione osmotica. Il rapporto tra pressione sanguigna e pressione osmotica colloidale nei vasi sanguigni umani.

RFWAHRMT–Di coagulo di sangue rischio per la salute o trombosi Illustrazione medica come simbolo di un gruppo di cellule del sangue umano ammassate insieme da sticky piastrine e fibrina come

RMT953C1–La trasfusione di sangue tra due persone, J. Roussel, 1876. Inizio con Harvey's esperimenti con la circolazione del sangue, ricerca in materia di trasfusioni di sangue è iniziata nel XVII secolo, con successo esperimenti di trasfusione tra gli animali. Tuttavia, successivi tentativi da parte dei medici alla trasfusione di sangue animale in esseri umani hanno dato variabile, spesso mortali, i risultati. Trasfusioni precoce tra gli esseri umani sono stati rischiosa e molti hanno causato la morte del paziente. Non è stato fino al 1901, quando l'austriaco Karl Landsteiner scoperto il sangue umano e i gruppi che le trasfusioni di sangue è diventato più sicuro.

RF2EHC258–Le cellule del sangue umano, viste al microscopio, sono ingrandite in media 600 volte. Illustrazione del 19 ° secolo. Germania. Sfondo bianco.

RF2BTGNWW–Una rappresentazione tipica dei globuli rossi o dei globuli rossi della rana, con le sue parti marcate. Cellule del sangue umano, mancano di un nucleo al centro
RF2XMBF56–Cellule ematiche umane sotto microscopio leggero, colorate con colorazione Giemsa per ingrandimento di 40 volte

RF2AX2G82–Una serie di campioni di sangue umano in un laboratorio medico pronto per essere testato. Contesto sanitario 3D illustrazione.

RFE8P6CX–La malaria spore spostare dalla zanzara al sangue umano flusso. le spore dividono molte volte e produrre grandi numeri di s

RF2XKD62P–Campioni di sangue umano sotto una lente d'ingrandimento. Illustrazione digitale, rendering 3D.

RMFF72BR–Trasfusione medica attrezzature, chiamato un separatore cellulare, che raccoglie il sangue umano e lo separa per raccogliere le cellule staminali e restituisce il resto del sangue al paziente in clinica londinese, Londra, Regno Unito. Le cellule staminali ematopoietiche verrà quindi utilizzato come un trapianto allogenico per una persona indipendente che ha il cancro del sangue (leucemia).

RMCRJKXE–Persone, esseri umani, esseri umani (Homo sapiens sapiens), umano vasi sanguigni. Destra: veine. Sinistra: arteria

RF2GG1HA8–Coagulo di sangue e trombosi concetto di illustrazione medica come un gruppo di cellule del sangue umano coagulate insieme da piastrine appiccicose e fibrina creazione.

RMT94YCB–Apparecchi per la trasfusione del sangue da LeBlonds e Collins, dal 1876. Inizio con Harvey's esperimenti con la circolazione del sangue, ricerca in materia di trasfusioni di sangue è iniziata nel XVII secolo, con successo esperimenti di trasfusione tra gli animali. Tuttavia, successivi tentativi da parte dei medici alla trasfusione di sangue animale in esseri umani hanno dato variabile, spesso mortali, i risultati. Trasfusioni precoce tra gli esseri umani sono stati rischiosa e molti hanno causato la morte del paziente. Non è stato fino al 1901, quando l'austriaco Karl Landsteiner scoperto il sangue umano e i gruppi che le trasfusioni di sangue è diventato più sicuro.

RFT7HJ48–Umano sistema circolatorio per i bambini. Colore del vettore cartoon illustrazione. Umano anatomia cardiovascolare regime. Tipi di cellule del sangue. La struttura di huma

RF2FK2DRK–Raccolta celle. Serie di cellule di raccolta vettoriale per la scienza dell'anatomia di microstruttura del sangue umano

RM2E74K7K–Sangue umano close up macro versamento di sangue frantumato in lavello bianco. Primo piano del DNA del sangue umano sulla scena del crimine.

RMFF72RB–Trasfusione medica attrezzature, chiamato un separatore cellulare, che raccoglie il sangue umano e lo separa per raccogliere le cellule staminali e restituisce il resto del sangue al paziente in clinica londinese, Londra, Regno Unito. Le cellule staminali ematopoietiche verrà quindi utilizzato come un trapianto allogenico per una persona indipendente che ha il cancro del sangue (leucemia linfoma, mieloma).

RFKABE14–Di coagulo di sangue simbolo della malattia e trombosi medical 3d illustrazione nozione come un gruppo di cellule del sangue umano ammassate insieme da piastrine appiccicosa.

RMT953BY–Apparecchi per la trasfusione del sangue da LeBlonds e Collins, dal 1876. Inizio con Harvey's esperimenti con la circolazione del sangue, ricerca in materia di trasfusioni di sangue è iniziata nel XVII secolo, con successo esperimenti di trasfusione tra gli animali. Tuttavia, successivi tentativi da parte dei medici alla trasfusione di sangue animale in esseri umani hanno dato variabile, spesso mortali, i risultati. Trasfusioni precoce tra gli esseri umani sono stati rischiosa e molti hanno causato la morte del paziente. Non è stato fino al 1901, quando l'austriaco Karl Landsteiner scoperto il sangue umano e i gruppi che le trasfusioni di sangue è diventato più sicuro.